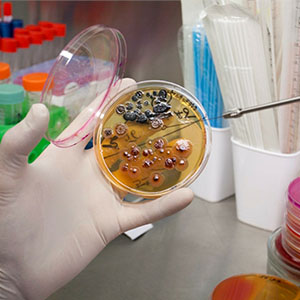
Бактериологические исследования

Барановичская районная ветеринарная станция Учреждение
Ветеринарные услуги, консультация. Лечение, профилактика, вакцинация, лабораторные исследования. Ветеринарно-санитарный надзор.
-
+375 (163) 67 74...arrow_drop_down
- +375 (163) 67 74 42 (Приемная/факс)
- +375 (163) 67 74 49 (Бухгалтерия, специалист по закупкам)
- +375 (163) 60 42 48 (Ветеринарные врачи)
- +375 (163) 63 19 63 (Начальник)
- +375 (163) 63 64 36 (Заместитель начальника)
Предоставление ветеринарных услуг
Барановичская районная ветеринарная станция Учреждение
Ветеринарные препараты для всех видов животных. Ветеринарные аптеки.
-
+375 (163) 46 84...arrow_drop_down
- +375 (163) 46 84 90 (Тел.)
- +375 (163) 46 84 89 (Тел.)
- +375 (163) 61 30 09 (Отдел реализации)
Березинская районная ветеринарная станция ГУ
Райветстанция. Профилактика, лечение, диагностика бактериальных, вирусных и внутренних незаразных заболеваний сельскохозяйственных и домашних животных.
-
+375 (1715) 6 19...arrow_drop_down
- +375 (1715) 6 19 82 (Приемная)
- +375 (1715) 6 45 37 (Начальник)
- +375 (1715) 6 41 34 (Главный бухгалтер)
Березовская районная ветеринарная станция Учреждение
Ветеринарные услуги, консультация. Лечение, профилактика, вакцинация, лабораторные исследования, ветеринарно-санитарный надзор.
-
+375 (1643) 3 88...arrow_drop_down
- +375 (1643) 3 88 14 (Приемная/факс)
- +375 (1643) 3 88 32 (Главный бухгалтер, юрист)
- +375 (1643) 4 69 82 (Прием животных)
Выдача ветеринарных сопроводительных документов на продукцию
Березовская районная ветеринарная станция Учреждение
Борисовская районная ветеринарная станция ГУ
Предупреждение и ликвидация заразных и незаразных заболеваний животных (включая пушных зверей, рыб, пчел) . Помощь мелким, крупным животным. Лабораторные исследования. Продажа ветпрепаратов. Обрезка копыт. УЗИ КРС.
-
+375 (177) 94 28...arrow_drop_down
- +375 (177) 94 28 34 (Тел.)
- +375 (177) 78 68 09 (Тел.)
Брагинская ветеринарная станция Учреждение
Предупреждение и ликвидация заразных и незаразных заболеваний животных. Лабораторные исследования. Продажа ветпрепаратов. Обрезка копыт.
-
+375 (2344) 3 95...arrow_drop_down
- +375 (2344) 3 95 87 (Бухгалтерия)
- +375 (2344) 3 91 82 (Лаборатория)
- +375 (2344) 3 99 37 (Врачи - эпизоотологи)
- +375 (2344) 3 15 86 (Приемная, факс)
Ветеринарная клиника ИП Ломакин М. П.
Высококвалифицированная помощь для Вашего питомца. Консультация, диагностика, лечение, вакцинация, кастрация, стерилизация, чипирование кошек, собак и других животных. Гигиенические услуги. Выдача ветеринарного паспорта на животное.
-
+375 (29) 559 22...arrow_drop_down
- +375 (29) 559 22 12 (Мобильный)
- +375 (177) 75 75 33 (Тел.)
- +375 (29) 655 20 39 (Мобильный)
Ветеринарные и специализированные услуги. Квалифицированная консультация. Лечение, профилактика, вакцинация, лабораторные исследования, ветеринарно - санитарный надзор.
-
+375 (1771) 3 7...arrow_drop_down
- +375 (1771) 3 71 90 (Приемная/факс)
- +375 (1771) 3 89 53 (Начальник)
- +375 (1771) 5 24 74 (Заместитель начальника)
- +375 (1771) 3 79 16 (Бухгалтерия)
- +375 (1771) 5 54 80 (Ветеринарные специалисты, юрист)
Вилейская участковая ветеринарная лечебница Вилейская райветстанция
Первичный прием, консультация ветеринара, хирургические манипуляции, терапевтические манипуляции, вакцинация домашних животных, люминесцентная диагностика, выдача ветеринарных паспортов.
-
+375 (1771) 2 22...arrow_drop_down
- +375 (1771) 2 22 23 (Тел.)
Витебская городская ветеринарная станция
Витебская горветстанция. Ветеринарные и специализированные услуги. Квалифицированная консультация. Лечение, профилактика, вакцинация, лабораторные исследования, ветеринарно-санитарный надзор.
-
+375 (212) 48 09...arrow_drop_down
- +375 (212) 48 09 87 (тел.)
Волковысская районная ветеринарная станция ГУ
Ветеринарные и специализированные услуги. Квалифицированная консультация. Лечение, профилактика, вакцинация, лабораторные исследования, ветеринарно-санитарный надзор.
-
+375 (1512) 9 70...arrow_drop_down
- +375 (1512) 9 70 22 (Приемная)
- +375 (1512) 9 56 91 (Руководитель)
- +375 (1512) 5 10 02 (Кабинет специалистов)
- +375 (1512) 2 48 36 (Райветлаборатория)
- +375 (1512) 5 10 04 (ЛВС рынок)
- +375 (1512) 5 10 05 (Горветстанция)
- +375 (1512) 6 20 98 (Участковая ветлечебница (Россь))
Предоставление ветеринарных услуг
Волковысская районная ветеринарная станция ГУ
Воложинская районная ветеринарная станция ГУ
Предупреждение и ликвидация заразных и незаразных заболеваний животных в с/х организациях района и личных подсобных хозяйствах граждан.
-
+375 (1772) 5 55...arrow_drop_down
- +375 (1772) 5 55 19 (тел.)
Предоставление ветеринарных услуг
Воложинская районная ветеринарная станция ГУ
Гомельская городская ветеринарная станция Учреждение
Ветеринарные и специализированные услуги. Квалифицированная консультация. Лечение, профилактика, вакцинация, лабораторные исследования, ветеринарно-санитарный надзор.
-
+375 (232) 50 53...arrow_drop_down
- +375 (232) 50 53 49 (приемная)
- +375 (232) 50 53 36 (бухгалтерия)
- +375 (232) 31 59 98 (заместитель директора)
Предоставление ветеринарных услуг
Гомельская городская ветеринарная станция Учреждение
Гостиница для животных ГП Фауна Города
Гостиница для животных. Комфортные условия проживания. Временное содержание, оказание ветеринарных услуг, стерилизация, кастрация, вакцинация и др., послеоперационный уход. Груминг.
-
+375 (17) 324 70...arrow_drop_down
- +375 (17) 324 70 79 (Тел.)
- +375 (29) 395 09 25 (Мобильный)
Гродненская районная ветеринарная станция
Лабораторная диагностика животных, птиц, болезней пчел и рыб. Ультразвуковая диагностика. Диагностика патологий беременности крупного рогатого скота.
-
+375 (152) 66 80...arrow_drop_down
- +375 (152) 66 80 04 (Приемная)
- +375 (152) 66 80 09 (Начальник)
- +375 (152) 66 80 43 (Аптека)
- +375 (152) 65 71 24 (Лаборатория)
- +375 (152) 66 80 27 (Заместитель начальника)
- +375 (152) 66 80 59 (Специалисты)
- +375 (152) 66 80 71 (Бухгалтерия)
- +375 (152) 68 09 03 (Скидельская УВЛ/Лаборатория ВСЭ)
- +375 (152) 68 09 57 (Сопоцкинская УВЛ)
Добрушская районная ветеринарная станция ГУ
Райветстанция. Ветеринарные услуги. Лечение, профилактика, вакцинация, лабораторные исследования.
-
+375 (2333) 5 63...arrow_drop_down
- +375 (2333) 5 63 79 (Ветаптека)
- +375 (2333) 9 54 03 (Городская ветстанция)
- +375 (2333) 2 45 22 (Тереховская участковая ветлечебница (г.п. Треховка, пер. Советский, 114))
- +375 (2333) 9 54 02 (Факс)
- +375 (2333) 2 36 50 (Приемная, отдел кадров)
- +375 (2333) 2 30 74 (Бухгалтерия)
Докшицкая районная ветеринарная станция ГЛПУ
Докшицкая райветстанция. Ветеринарные и специализированные услуги. Квалифицированная консультация. Лечение, профилактика, вакцинация, лабораторные исследования, ветеринарно-санитарный надзор.
-
+375 (2157) 5 17...arrow_drop_down
- +375 (2157) 5 17 18 (Главный врач)
- +375 (2157) 5 17 21 (Бухгалтерия)
- +375 (2157) 5 17 19 (Диагностич. отдел)
Дрогичинская районная ветеринарная станция Учреждение
Райветстанция. Ветеринарные услуги. Лечение, профилактика, вакцинация.
-
+375 (1644) 4 03...arrow_drop_down
- +375 (1644) 4 03 08 (Общий, факс)
- +375 (1644) 4 13 20 (Тел.)
- +375 (1644) 4 93 79 (Участковая ветеринарная лечебница)
Друг Ветеринарный центр ЧТУП по оказанию услуг
Ветеринарный центр ДРУГ. Терапия. Узи. Вакцинация и чипирование. Хирургия. Дерматология. Гинекология. Офтальмология. Стоматология. Травматология. Стрижка собак, кошек.
-
+375 (17) 363 81...arrow_drop_down
- +375 (17) 363 81 81 (тел.)
- +375 (29) 535 24 45 (МТС )
- +375 (29) 973 02 54 (А1)
Житковичская районная ветеринарная станция Учреждение
Ветеринарные услуги, ветеринарно-санитарный надзор, ветеринарная клиника, ветаптека, ветеринарная лаборатория. Консультации, лечение, профилактика, вакцинация домашних и сельскохозяйственных животных.
-
+375 (2353) 5 39...arrow_drop_down
- +375 (2353) 5 39 46 (Главный вет. врач)
- +375 (2353) 5 39 41 (Заместитель)
- +375 (2353) 5 39 44 (Юрист)
- +375 (2353) 5 39 45 (Главный бухгалтер)
- +375 (2353) 5 39 40 (Житковичская ветлечебница)
- +375 (2353) 7 52 31 (Туровская ветлечебница)
- +375 (2353) 9 13 69 (Лаборатория)
Предоставление ветеринарных услуг
Житковичская районная ветеринарная станция Учреждение
Ивьевская районная ветеринарная станция ГУ
Лечение сельскохозяйственных животных. Вакцинирование животных, выдача ветеринарных паспортов. Услуги лабораторной диагностики.
-
+375 (1595) 6 38...arrow_drop_down
- +375 (1595) 6 38 31 (Приемная, отдел кадров)
- +375 (1595) 6 15 85 (Юрист)
- +375 (1595) 6 38 27 (Начальник)
Калинковичская районная ветеринарная станция Государственное учреждение
Калинковичская райветстанция. Ветеринарные услуги. Лечение, профилактика, вакцинация, лабораторные исследования.
-
+375 (2345) 5 45...arrow_drop_down
- +375 (2345) 5 45 66 (Начальник)
- +375 (2345) 3 53 79 (Приемная)
- +375 (2345) 2 52 85 (Бухгалтерия)
- +375 (2345) 5 28 06 (Город. ветстанция)
- +375 (2345) 2 65 18 (Город. ветстанция)
- +375 (2345) 3 04 39 (Агрохимич. лаборатория)
- +375 (2345) 3 13 43 (Лаборатория вет.-сан. экспертизы)
- +375 (2345) 5 21 39 (Ветеринарные врачи)
Предоставление ветеринарных услуг
Калинковичская районная ветеринарная станция Государственное учреждение
Каменецкая районная ветеринарная станция Учреждение
Ветеринарные услуги, консультация. Лечение, профилактика, вакцинация, лабораторные исследования, ветеринарно-санитарный надзор.
-
+375 (1631) 7 60...arrow_drop_down
- +375 (1631) 7 60 36 (Начальник)
- +375 (1631) 7 63 29 (Приемная)
- +375 (1631) 7 63 36 (Врачи)
- +375 (1631) 3 71 56 (Участковая лечебница г. Каменец УВЛ Каменюки)
- +375 (1631) 9 49 55 (Верховичская участковая лечебница)
- +375 (1631) 7 15 69 (г. Высокое лечебница)
Предоставление ветеринарных услуг
Каменецкая районная ветеринарная станция Учреждение
Клецкая районная ветеринарная станция ГУ
Ветеринарные услуги, консультации. Лечение, профилактика, вакцинации. Лабораторные исследования.
-
+375 (1793) 6 22...arrow_drop_down
- +375 (1793) 6 22 94 (Приемная/факс)
- +375 (1793) 6 19 97 (Начальник)
- +375 (1793) 6 53 86 (Общий кабинет ветврачей)
- +375 (1793) 6 53 89 (Бухгалтерия)
Кобринская районная ветеринарная станция Учреждение
Ветеринарные услуги, консультация. Лечение, профилактика, вакцинация, лабораторные исследования, ветеринарно-санитарный надзор.
-
+375 (1642) 5 33...arrow_drop_down
- +375 (1642) 5 33 19 (Начальник)
- +375 (1642) 6 60 13 (Бухгалтерия/факс)
- +375 (1642) 3 85 26 (Юрисконсульт)
- +375 (1642) 3 48 22 (Ветеринарная клиника)
Копыльская районная ветеринарная станция ГУ
Ветеринарные и специализированные услуги. Квалифицированные консультации. Лечение, вакцинирование, ветеринарно-санитарный надзор.
-
+375 (1719) 2 89...arrow_drop_down
- +375 (1719) 2 89 36 (Приемная. Руководитель. Факс.)
- +375 (1719) 2 04 31 (Бухгалтер)
- +375 (1719) 5 58 83 (Тел.)
Предоставление ветеринарных услуг
Копыльская районная ветеринарная станция ГУ
Крупская районная ветеринарная станция ГУ
Квалификационная консультация. Лечение, профилактика, вакцинация. Диагностика бактериальных, вирусных и внутренних незаразных заболеваний сельскохозяйственных и домашних животных. Ветстанция.
-
+375 (1796) 2 45...arrow_drop_down
- +375 (1796) 2 45 07 (Бухгалтерия)
- +375 (1796) 4 24 60 (Специалист по кадрам)
- +375 (1796) 2 16 14 (Врачи)
- +375 (1796) 2 01 43 (Лаборатория)
Лельчицкая районная ветеринарная станция с ветеринарной лабораторией Учреждение
Ветеринарные услуги, ветеринарно-санитарный надзор. Лабораторные исследования. Вакцинация, профилактика, лечение, консультации.
-
+375 (2356) 2 12...arrow_drop_down
- +375 (2356) 2 12 87 (Тел./факс)
- +375 (2356) 2 12 84 (Главный вет. врач)
- +375 (2356) 2 12 85 (Вет. врачи)
Предоставление ветеринарных услуг
Лельчицкая районная ветеринарная станция с ветеринарной лабораторией Учреждение
Логойская районная ветеринарная станция ГУ
Ветеринарные и специализированные услуги. Квалифицированная консультация. Лечение, профилактика, вакцинация, лабораторные исследования, ветеринарно-санитарный надзор.
-
+375 (1774) 7 83...arrow_drop_down
- +375 (1774) 7 83 44 (Начальник)
- +375 (29) 702 72 73 (Начальник)
- +375 (1774) 7 81 75 (Общий отдел)
- +375 (1774) 7 81 46 (Тел.)
- +375 (33) 673 85 40 (Заместитель начальника)
- +375 (1774) 7 81 36 (Ветеринарный участок г. Логойска)
- +375 (1774) 2 29 47 (Ветеринарный участок г.п. Плещеницы)
- +375 (1774) 7 81 47 (Лаборатория)
Выдача ветеринарного паспорта животного
Логойская районная ветеринарная станция ГУ
Выдача ветеринарно-санитарного паспорта пасеки
Логойская районная ветеринарная станция ГУ
Консультация в области ветеринарии, диагностика, лечение, лечебно-профилактические мероприятия, вакц
Логойская районная ветеринарная станция ГУ
Лоевская ветеринарная станция Учреждение
Райветстанция. Ветеринарные услуги. Лечение, профилактика, вакцинация, лабораторные исследования. Продажа ветпрепаратов. Обрезка копыт.
-
+375 (2347) 2 01...arrow_drop_down
- +375 (2347) 2 01 70 (Приемная)
- +375 (2347) 2 09 84 (Бухгалтерия)
- +375 (2347) 2 18 34 (Юрисконстульт)
 в избранном
в избранном